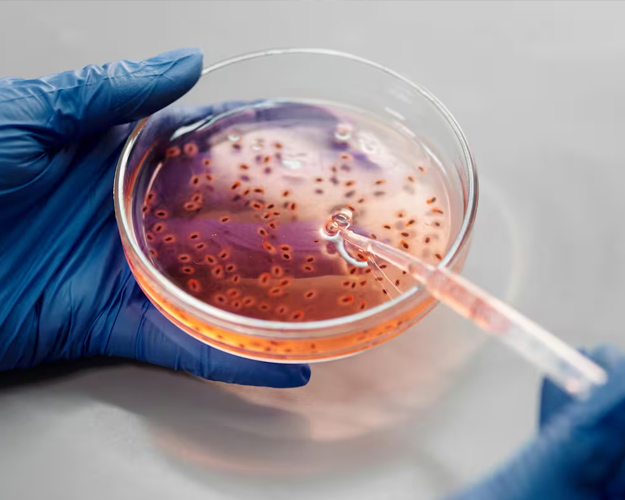

Los Centros para el Control y Prevención de Enfermedades (CDC) informaron que al menos 28 personas se han infectado con la cepa de Listeria en 12 en Estados Unidos. Todas han sido hospitalizadas.
Al menos dos muertes se han reportado, una en Illinois y otra en Nueva Jersey. Al menos 16 personas reportaron haber consumido carnes cortadas en lonchas en mostradores de delicateses. No hay información que demuestre que las personas se están enfermando por consumir fiambres envasados.
Entre junio y julio, se detectaron 28 casos en 12 estados, aunque los especialistas no descartan la posibilidad de que el número de afectados sea aún mayor, dado que se puede tardar semanas en determinar si una persona ingirió un alimento contaminado con esa bacteria.
Recomiendan que deben evitar comer carnes cortadas en los mostradores, a menos que se calienten o estén humeantes justo antes de servir.

En Estados Unidos investigan brote de Listeria
La listeriosis es una infección grave. Proviene de una bacteria llamada Listeria monocytogenes. Cada año mil 600 personas contraen listeriosis y unas 260 mueren.
“Los CDC, funcionarios de salud pública y reguladores de varios estados y el Servicio de Inspección y Seguridad Alimentaria del Departamento de Agricultura (FSIS, por sus siglas en inglés) están recopilando diferentes tipos de datos para identificar la fuente alimentaria de un brote multiestatal de infecciones por listeria monocytogenes”, explicaron la autoridades.
Las mujeres embarazadas podrían correr el riesgo de provocar aborto espontáneo, muerte fetal, parto prematuro o una infección potencialmente mortal del recién nacido.
Los síntomas, si se agrava la enfermedad, suelen comenzar entre 1 y 4 semanas luego de comer alimentos contaminados con Listeria. Pueden comenzar el mismo día o hasta 70 días después.

La listeriosis se diagnostica cuando un cultivo bacteriano detecta Listeria en un tejido o líquido corporal, como sangre, líquido cefalorraquídeo o la placenta.